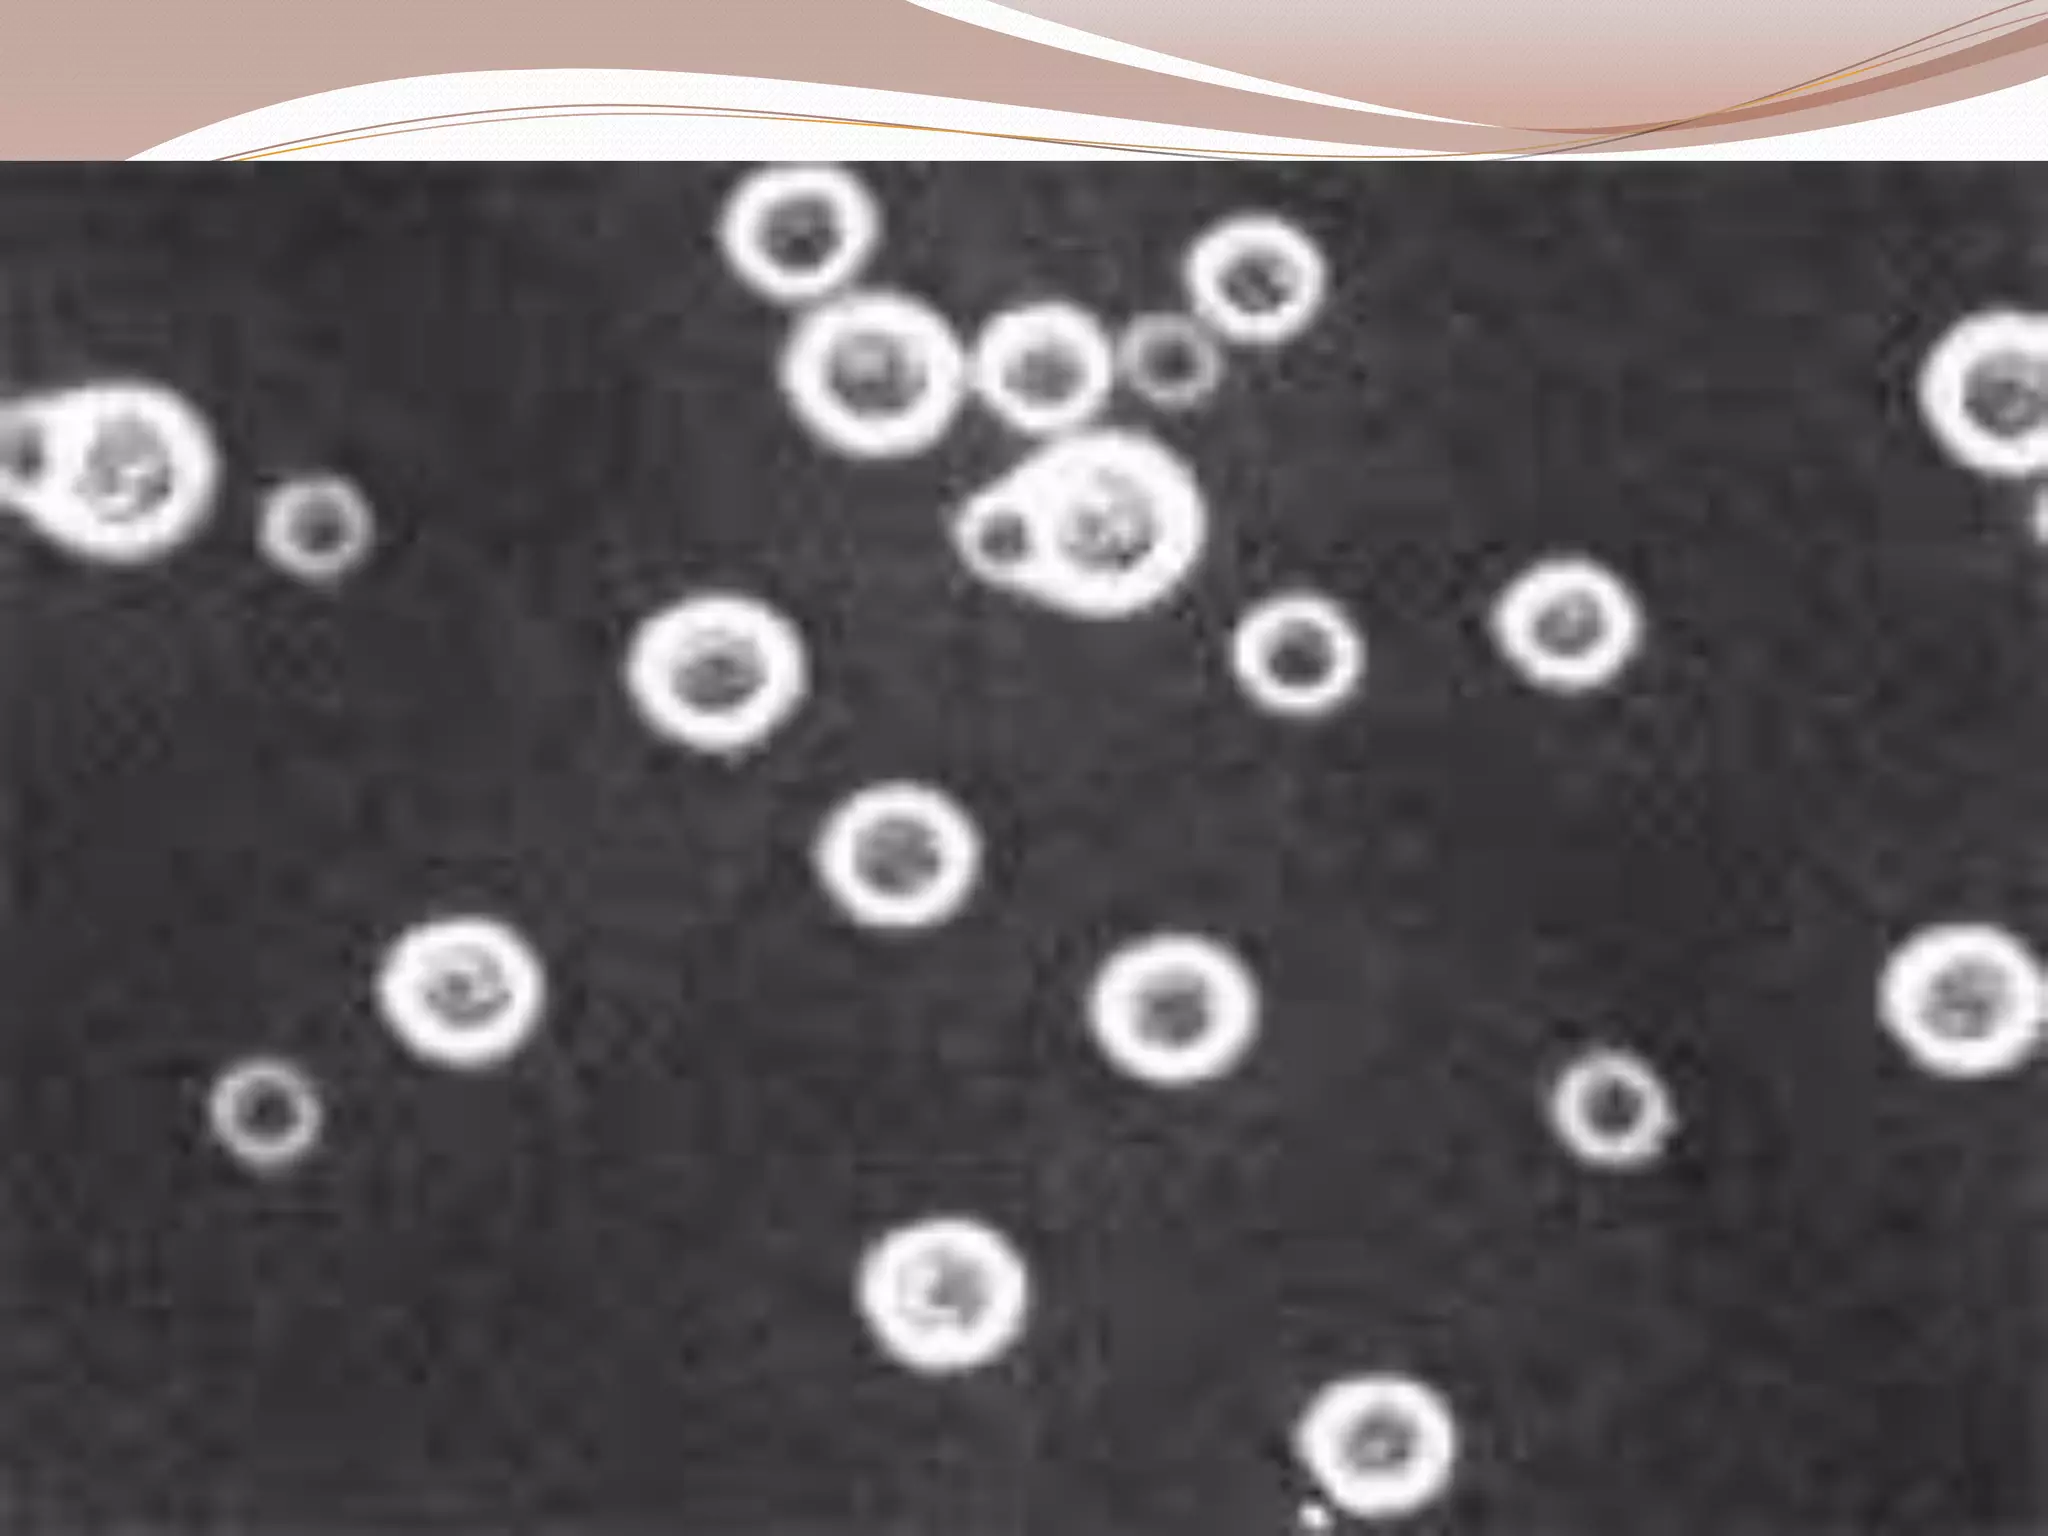

This document provides information on various special stains used to identify microorganisms and cellular structures under the microscope. It discusses stains used for flagella, metachromatic granules, spirochetes, Chlamydia, rickettsia, and fungi. Specific stains covered include Wright's Giemsa, Gram, acid-fast, silver, toluidine blue, calcofluor white, acridine orange, auramine phenol, and lactophenol cotton blue. Procedures for each stain are provided along with what structures or organisms they help identify.